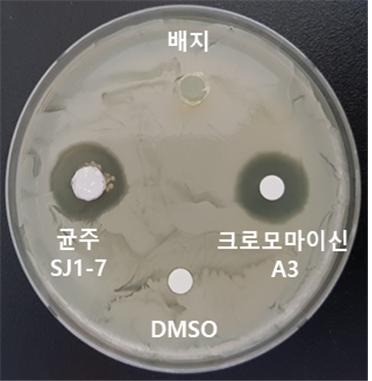
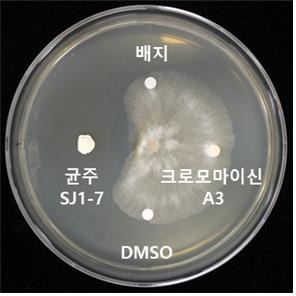

국립생물자원관, 국내 토양 미생물에서 항암제 등에 쓰이는 균주 발견
값비싼 항생물질의 국내 대량생산 가능성 열려
환경부 소속 국립생물자원관은 암이나 각종 종양 치료제 개발에 쓰이는 '크로모마이신 에이3(Chromomycin A3)'를 합성하는 균주를 최근 우리나라 토양에서 찾았다고 밝혔다.
'크로모마이신 에이3'는 흙 속의 미생물에서 뽑아낸 항생물질로 1g에 약 9천만 원이 넘으며, 국내에서는 생산되지 않아 수입에 의존하고 있다.
이번 연구는 자생 미생물에서 '크로모마이신 에이3'를 합성하는 균주를 발견해 다국적기업에서 판매하고 있는 고가의 항생물질을 국내에서 대체할 수 있는 기반을 마련했다는 데 의미가 있다.

국립생물자원관은 2018년부터 환경과 인체에 유해한 영향을 주는 항생제 내성균, 병원성 세균 등의 생장을 억제할 수 있는 토양미생물을 발굴하고, 항균물질을 분리하는 연구를 진행하고 있다.
토양에는 과도한 항생제의 사용 등으로 오염된 유해미생물에 대항하여 그들의 생장을 억제하는 다양한 유용미생물이 존재한다.
이번에 발견된 균주는 우리나라 토양에서는 처음으로 찾은 것으로 '스트렙토마이세스 그리세우스(Streptomyces griseus) 에스제이(SJ)1-7'로 이름이 붙여졌다. 국립생물자원관 연구진은 올해 4월 유전체 해독을 끝내고, 최근 특허를 출원했다.
스트렙토마이세스 그리세우스는 결핵 치료에 사용되는 스트렙토마이신을 분비하며, 크로모마이신과 같은 항생물질도 합성하는 것으로 알려졌다.
또한, 아수가마이신 등 32개의 활성물질 생합성 유전자를 더 포함하고 있어 다양한 활성물질을 얻을 수 있을 것으로 기대된다.
한편, 스트렙토마이세스 그리세우스 균주는 균핵병, 궤양병 등 여러 식물의 병원균을 사멸하는데 효과가 있는 것으로 확인되어, 향후 친환경 식물병 방제제 등의 개발을 진행할 수 있을 것으로 보인다.
배연재 국립생물자원관장은 "국내 토양에는 다양한 미생물이 서식하고 있으며, 여러 가지 병원균의 생장을 억제하는 미생물과 활성물질을 찾기 위한 연구를 집중할 계획"이라고 밝혔다.
<저작권자 ⓒ 연합국민뉴스, 무단 전재 및 재배포 금지>
조한열 기자 다른기사보기



